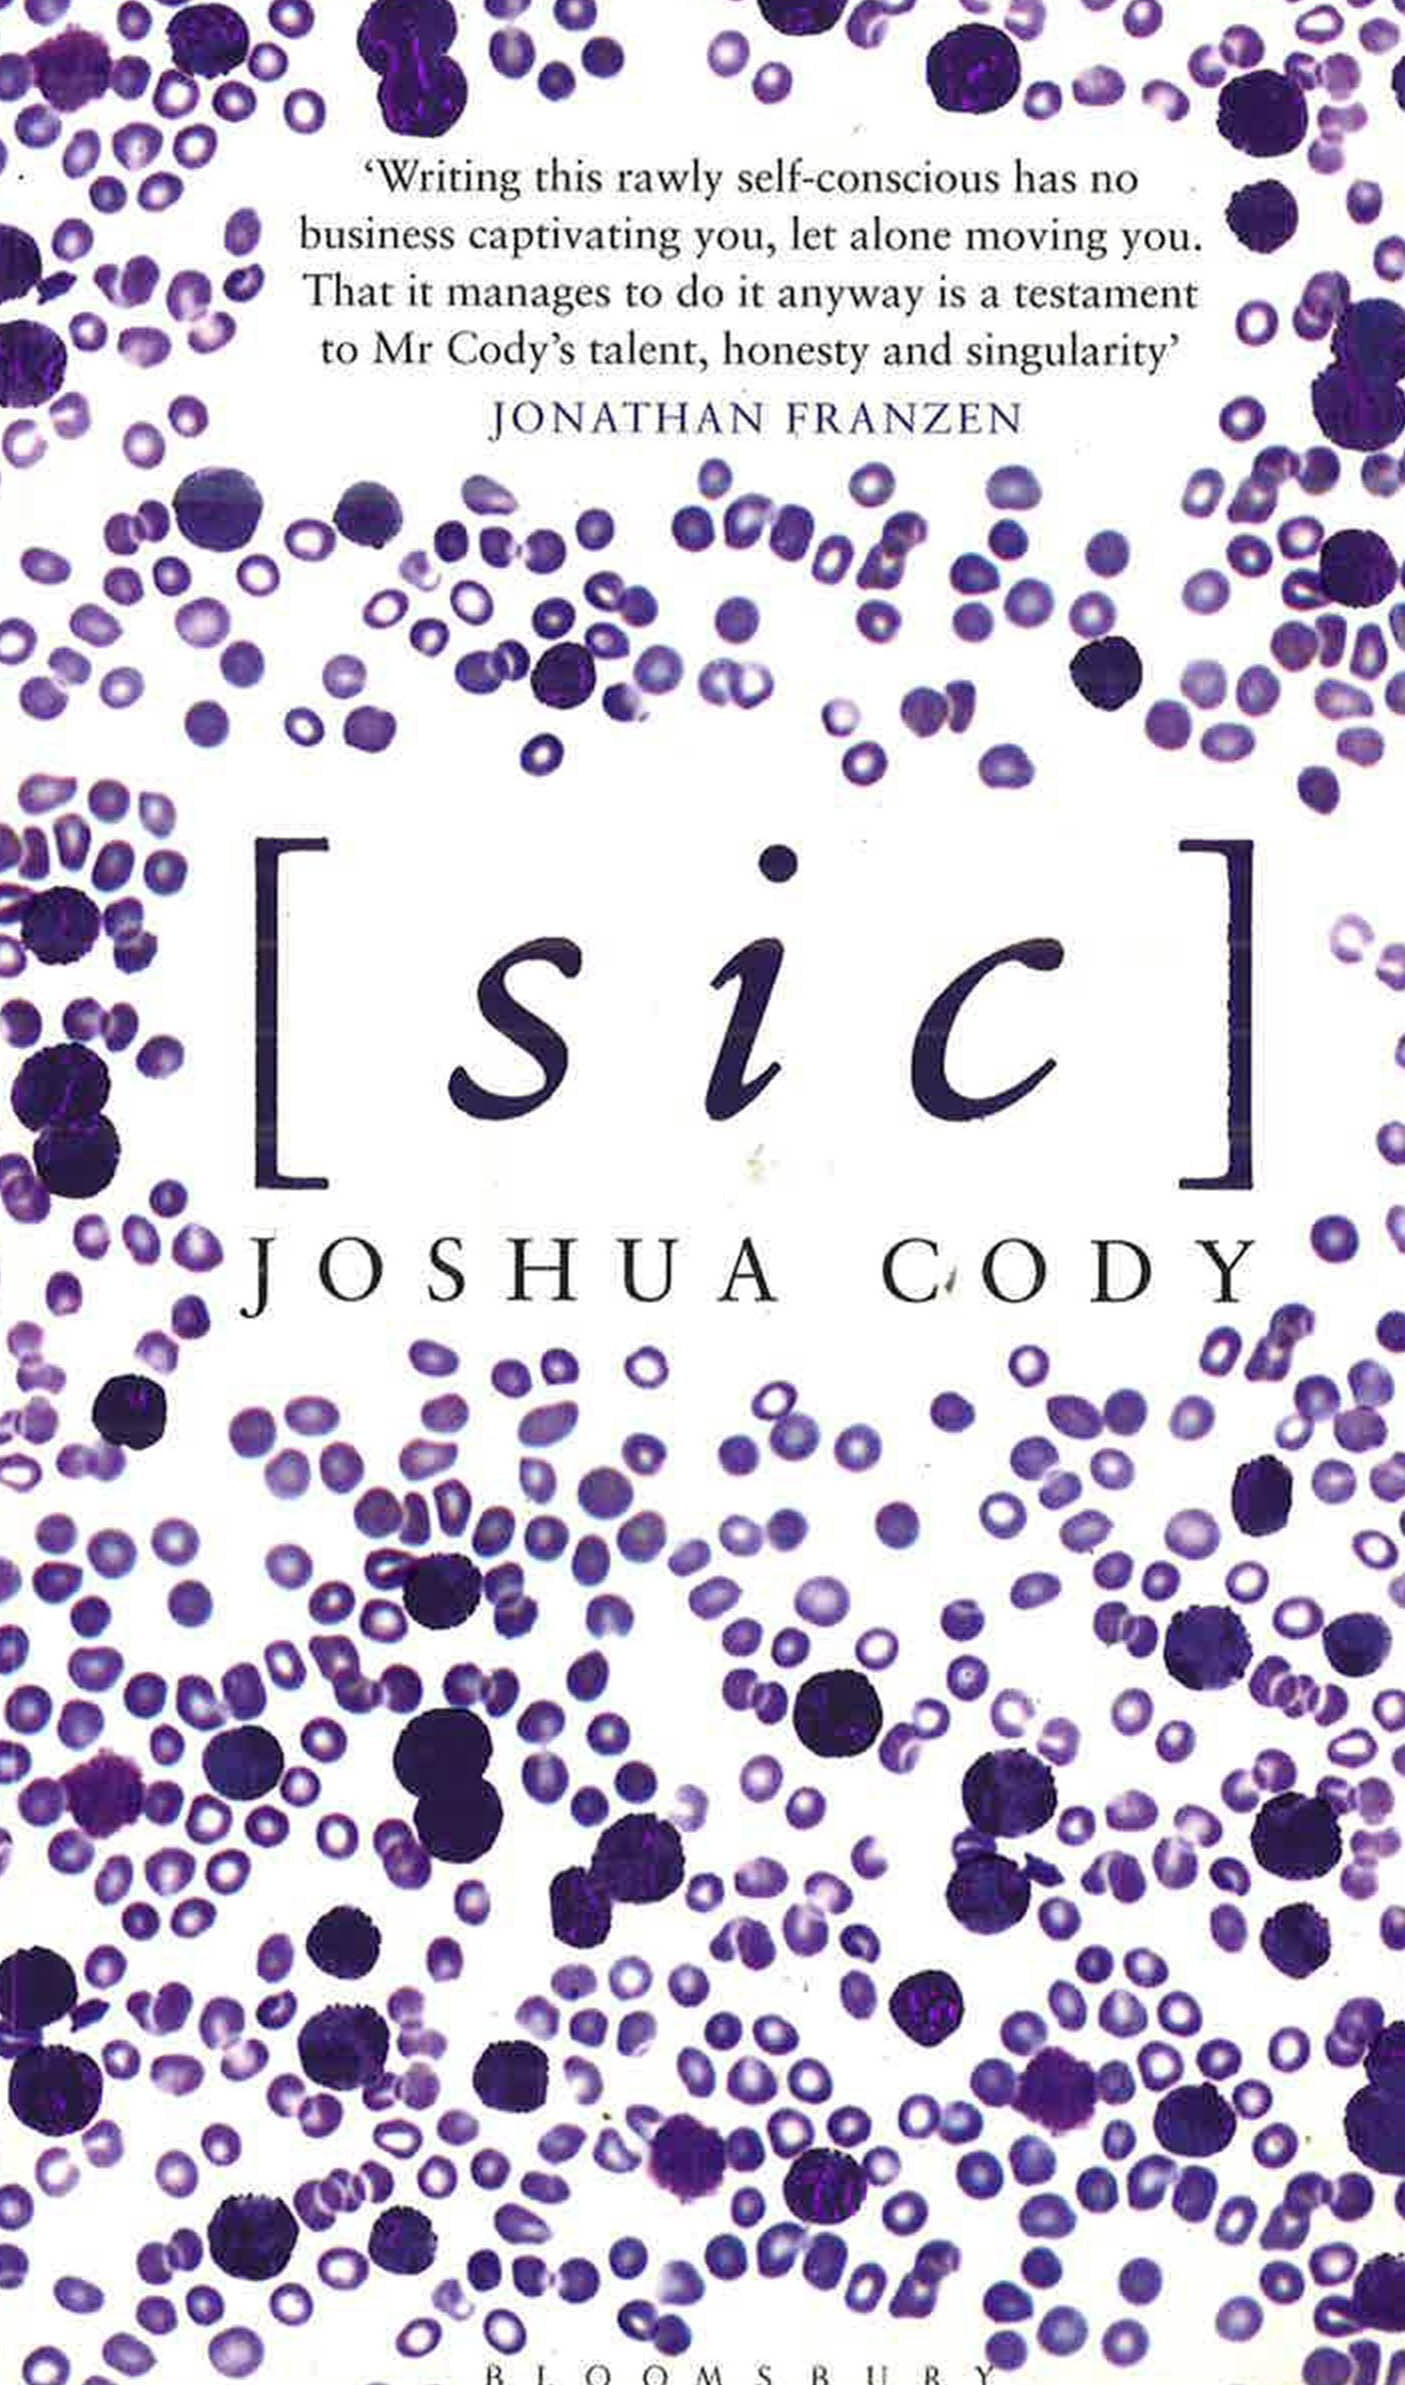

PRODUCT OVERVIEW
- ISBN 9781408821374
- Categories [2022], Board Books, BX, BXOS, Children's Books, Joshua Cody, NF BIO, Paperback, RM 10 - RM 19.99
- Author(s) Joshua Cody
- Publisher Bloomsbury Publishing Plc
- Format Paperback
- Dimensions 13.5cm x 2.5cm x 21.6cm
- Weight 0.297 kg
product description
Joshua Cody was about to receive his PhD from Columbia University when he was diagnosed with cancer. He underwent six months of chemotherapy. The treatment failed. Expectations for survival plummeted. After consulting with several oncologists, he embarked on a risky course of high-dose chemotherapy, full body radiation, and an autologous bone marrow transplant.
In a fevered, mesmerising voice, Joshua chronicles his battle against cancer with breathtaking audacity. Slaloming effortlessly between references to Ezra Pound, The Rolling Stones, Beethoven, and even Brett Favre, Joshua takes readers through his struggle in a memoir unlike any other. He captures the rage that can often accompany illness and the paradoxical will towards self-destruction. To wit, midway through his chemotherapy treatment, he leaves the hospital, goes to his regular bar, does cocaine in the bathroom, then meets a woman on the street and brings her home. With writing that is as fresh and beguiling as it is brave and revealing, Joshua Cody has created a book that gives readers a long glimpse into a gorgeous, dark thrashing in the forecourt of death.
Literary, hallucinatory and at times uncomfortable reading, [sic] is ultimately a celebration of art, language and life.